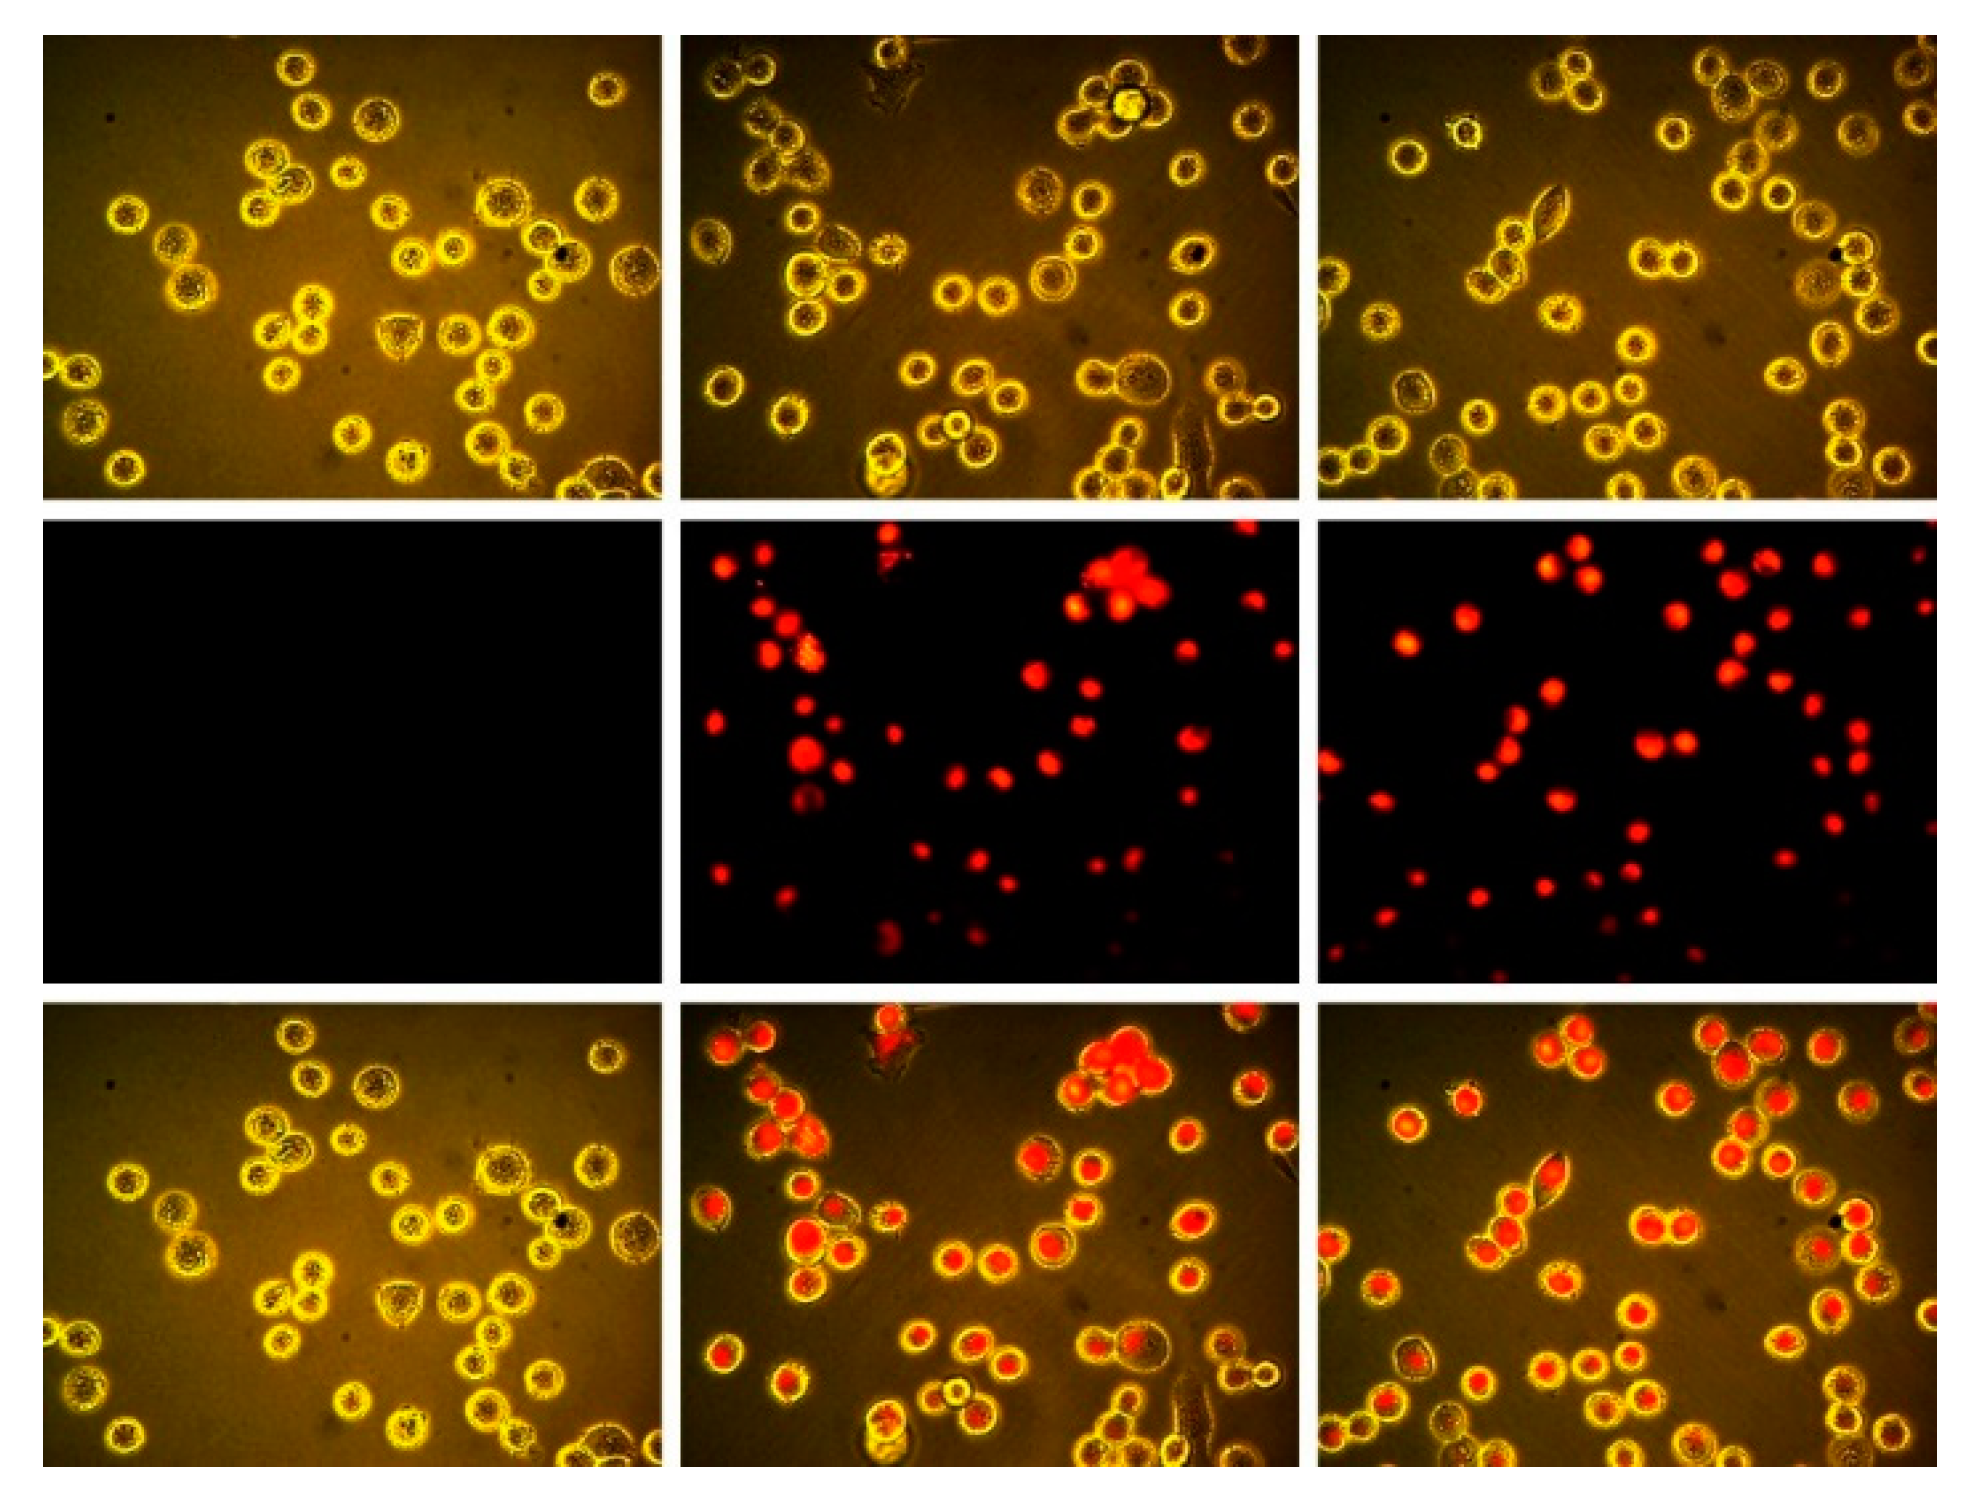
Molecules 24 03832 g004 550

Synthesis of the C3 and C1 Constitutional Isomers of Trifluorosubphthalocyanine and Their Fluorescence within MDA-MB-231 Breast Tumor Cells
Abstract
:1. Introduction
2. Results and Discussion
2.1. Synthesis and Characterization of C3 and C1 Constitutional Isomers of Trifluorosubphthalcyanine
2.2. Photophysical Properties of Subphthalocyanines
2.3. Epifluorescence Microscopy of Subphthalocyanines in MDA-MB-231 Breast Tumor Cells
3. Materials and Methods
3.1. General Considerations
3.2. Synthesis
3.3. Fluorescence Quantum Yield Determination
3.4. Cell Culture and Fluorescence Imaging
Supplementary Materials
Author Contributions
Funding
Conflicts of Interest
References
- Meller, A.; Ossko, A. Phthalocyaninartige Bor-Komplexe. Mon. Für Chem. Chem. Mon. 1972, 103, 150–155. [Google Scholar] [CrossRef]
- Torres, T. From subphthalocyanines to subporphyrins. Angew. Chem. Int. Ed. 2006, 45, 2834–2837. [Google Scholar] [CrossRef] [PubMed]
- Claessens, C.G.; Gonzalez-Rodriguez, D.; Rodriguez-Morgade, M.S.; Medina, A.; Torres, T. Subphthalocyanines, subporphyrazines, and subporphyrins: Singular nonplanar aromatic systems. Chem. Rev. 2014, 114, 2192–2277. [Google Scholar] [CrossRef] [PubMed]
- Montero-Campillo, M.M.; Lamsabhi, A.M.; Mó, O.; Yáñez, M. Photochemical behavior of beryllium complexes with subporphyrazines and subphthalocyanines. J. Phys. Chem. A 2016, 120, 4845–4852. [Google Scholar] [CrossRef]
- Morse, G.E.; Bender, T.P. Boron subphthalocyanines as organic electronic materials. Acs Appl. Mater. Interfaces 2012, 4, 5055–5068. [Google Scholar] [CrossRef]
- Plint, T.G.; Lessard, B.H.; Bender, T.P. Doping chloro boron subnaphthalocyanines and chloro boron subphthalocyanine in simple OLED architectures yields warm white incandescent-like emissions. Opt. Mater. 2018, 75, 710–718. [Google Scholar] [CrossRef]
- Morse, G.E.; Helander, M.G.; Maka, J.F.; Lu, Z.-H.; Bender, T.P. Fluorinated phenoxy boron subphthalocyanines in organic light-emitting diodes. Acs Appl. Mater. Interfaces 2010, 2, 1934–1944. [Google Scholar] [CrossRef]
- Sullivan, P.; Duraud, A.; Hancox, l.; Beaumont, N.; Mirri, G.; Tucker, J.H.R.; Hatton, R.A.; Shipman, M.; Jones, T.S. Halogenated boron subphthalocyanines as light harvesting electron acceptors in organic photovoltaics. Adv. Energy Mater. 2011, 1, 352–355. [Google Scholar] [CrossRef]
- Xu, H.; Jiang, X.J.; Chan, E.Y.M.; Fong, W.P.; Ng, D.K.P. Synthesis, photophysical properties and in vitro photodynamic activity of axially substituted subphthalocyanines. Org. Biomol. Chem. 2007, 5, 3987–3992. [Google Scholar] [CrossRef]
- Winckel, E.; Mascaraque, M.; Zamarrón, A.; Juarranz de la Fuente, Á.; Torres, T.; Escosura, A. Dual role of subphthalocyanine dyes for optical imaging and therapy of cancer. Adv. Funct. Mater. 2018, 28, 1705938. [Google Scholar] [CrossRef]
- Spesia, M.B.; Durantini, E.N. Synthesis and antibacterial photosensitizing properties of a novel tricationic subphthalocyanine derivative. Dyes Pigment. 2008, 77, 229–237. [Google Scholar] [CrossRef]
- Naidoo, C.; Kruger, C.A.; Abrahamse, H. Simultaneous photodiagnosis and photodynamic treatment of metastatic melanoma. Molecules 2019, 24, 3153. [Google Scholar] [CrossRef] [PubMed]
- Wong, R.C.H.; Lo, P.-C.; Ng, D.K.P. Stimuli responsive phthalocyanine-based fluorescent probes and photosensitizers. Coord. Chem. Rev. 2019, 379, 30–46. [Google Scholar] [CrossRef]
- Awaji, A.I.; Köksoy, B.; Durmuş, M.; Aljuhani, A.; Alraqa, S.Y. Novel hexadeca-substituted metal free and zinc(II) phthalocyanines; design, synthesis and photophysicochemical properties. Molecules 2018, 24, 77. [Google Scholar] [CrossRef]
- Bonnett, R. Photosensitizers of the porphyrin and phthalocyanine series for photodynamic therapy. Chem. Soc. Rev. 1995, 24, 19–33. [Google Scholar] [CrossRef]
- Müller, K.; Faeh, C.; Diederich, F. Fluorine in pharmaceuticals: Looking beyond intuition. Science 2007, 317, 1881. [Google Scholar] [CrossRef]
- Zhou, Y.; Wang, J.; Gu, Z.; Wang, S.; Zhu, W.; Aceña, J.L.; Soloshonok, V.A.; Izawa, K.; Liu, H. Next generation of fluorine-containing pharmaceuticals, compounds currently in phase II–III clinical trials of major pharmaceutical companies: New structural trends and therapeutic areas. Chem. Rev. 2016, 116, 422–518. [Google Scholar] [CrossRef]
- Wang, J.; Sánchez-Roselló, M.; Aceña, J.L.; del Pozo, C.; Sorochinsky, A.E.; Fustero, S.; Soloshonok, V.A.; Liu, H. Fluorine in pharmaceutical industry: Fluorine-containing drugs introduced to the market in the last decade (2001–2011). Chem. Rev. 2014, 114, 2432–2506. [Google Scholar] [CrossRef]
- Mei, H.; Han, J.; Fustero, S.; Medio-Simon, M.; Sedgwick, D.M.; Santi, C.; Ruzziconi, R.; Soloshonok, V.A. Fluorine-containing drugs approved by the FDA in 2018. Chem. A Eur. J. 2019, 25, 11797–11819. [Google Scholar] [CrossRef]
- McAuliffe, K.J.; Kaster, M.A.; Szlag, R.G.; Trivedi, E.R. Low-symmetry mixed fluorinated subphthalocyanines as fluorescence imaging probes in MDA-MB-231 breast tumor cells. Int. J. Mol. Sci. 2017, 18, 1177. [Google Scholar] [CrossRef]
- Sejdarasi, L.; McAuliffe, K.J.; Corbin, B.A.; Trivedi, E.R. Synthesis and characterization of mixed fluorinated phenylthio- subphthalocyanines. Chem. Sel. 2017, 2, 7417–7420. [Google Scholar] [CrossRef]
- Hamdoush, M.; Skvortsov, I.A.; Mikhailov, M.S.; Pakhomov, G.; Stuzhin, P.A. Perfluorinated subphthalocynine analogues containing fused 1,2,5-thiadiazole fragments. J. Fluor. Chem. 2017, 204, 31–36. [Google Scholar] [CrossRef]
- Farley, C.; Bhupathiraju, N.V.S.D.K.; John, B.K.; Drain, C.M. Tuning the structure and photophysics of a fluorous phthalocyanine platform. J. Phys. Chem. A 2016, 120, 7451–7464. [Google Scholar] [CrossRef] [PubMed]
- Guilleme, J.; González-Rodríguez, D.; Torres, T. Triflate-subphthalocyanines: Versatile, reactive intermediates for axial functionalization at the boron atom. Angew. Chem. Int. Ed. 2011, 50, 3506–3509. [Google Scholar] [CrossRef] [PubMed]
- Hanack, M.; Geyer, M. Synthesis and separation of structural isomers of tri-tert-butylsubphthalocyaninatophenylboron(III). J. Chem. Soc. Chem. Commun. 1994, 2253–2254. [Google Scholar] [CrossRef]
- Claessens, C.G.; Torres, T. Subphthalocyanine enantiomers: First resolution of a C-3 aromatic compound by HPLC. Tetrahedron Lett. 2000, 41, 6361–6365. [Google Scholar] [CrossRef]
- Morse, G.E.; Helander, M.G.; Stanwick, J.; Sauks, J.M.; Paton, A.S.; Lu, Z.-H.; Bender, T.P. Experimentally validated model for the prediction of the HOMO and LUMO energy levels of boronsubphthalocyanines. J. Phys. Chem. C 2011, 115, 11709–11718. [Google Scholar] [CrossRef]
- Gouterman, M.; Snyder, L.C.; Wagniere, G.H. Spectra of porphyrins: Part II. Four orbital model. J. Mol. Spectrosc. 1963, 11, 108–127. [Google Scholar] [CrossRef]
- Williams, A.T.R.; Winfield, S.A.; Miller, J.N. Relative fluorescence quantum yields using a computer-controlled luminescence spectrometer. Analyst 1983, 108, 1067–1071. [Google Scholar] [CrossRef]
Sample Availability: Samples of the compounds may be available from the authors upon request. |

© 2019 by the authors. Licensee MDPI, Basel, Switzerland. This article is an open access article distributed under the terms and conditions of the Creative Commons Attribution (CC BY) license (http://creativecommons.org/licenses/by/4.0/).
Share and Cite
L. Calandrino, R.; J. McAuliffe, K.; E. Dolmage, L.; R. Trivedi, E. Synthesis of the C3 and C1 Constitutional Isomers of Trifluorosubphthalocyanine and Their Fluorescence within MDA-MB-231 Breast Tumor Cells. Molecules 2019, 24, 3832. https://doi.org/10.3390/molecules24213832
L. Calandrino R, J. McAuliffe K, E. Dolmage L, R. Trivedi E. Synthesis of the C3 and C1 Constitutional Isomers of Trifluorosubphthalocyanine and Their Fluorescence within MDA-MB-231 Breast Tumor Cells. Molecules. 2019; 24(21):3832. https://doi.org/10.3390/molecules24213832
Chicago/Turabian StyleL. Calandrino, Rosemarie, Katherine J. McAuliffe, Lauren E. Dolmage, and Evan R. Trivedi. 2019. "Synthesis of the C3 and C1 Constitutional Isomers of Trifluorosubphthalocyanine and Their Fluorescence within MDA-MB-231 Breast Tumor Cells" Molecules 24, no. 21: 3832. https://doi.org/10.3390/molecules24213832
APA StyleL. Calandrino, R., J. McAuliffe, K., E. Dolmage, L., & R. Trivedi, E. (2019). Synthesis of the C3 and C1 Constitutional Isomers of Trifluorosubphthalocyanine and Their Fluorescence within MDA-MB-231 Breast Tumor Cells. Molecules, 24(21), 3832. https://doi.org/10.3390/molecules24213832

